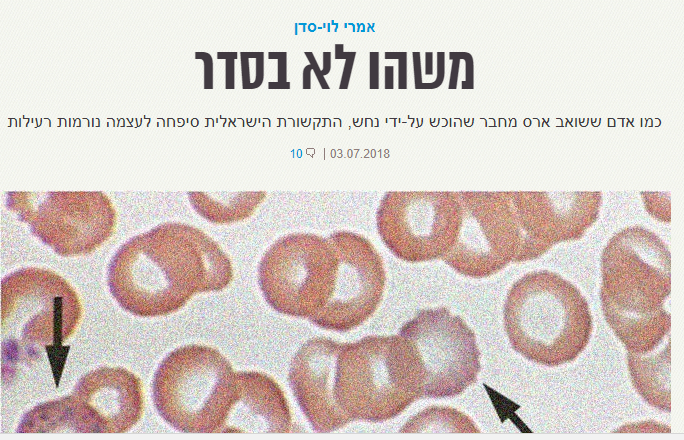

לא חלמתי על הג'וב הזה. שיחה אקראית ב"קרוסלה", בית-הקפה השכונתי ברחביה, עם מי שהיתה חניכה שלי בבני-עקיבא, הובילה אותי להיות עיתונאי. לא היתה לי אפליקציית חדשות אחת בסמאטרפון, לא עניינו אותי אסונות בנפאל, מיהו שר התקשורת ומה קורה בשיחות הגרעין בין זריף לקרי. הטיימינג היה "מושלם": קצת אחרי חטיפת שלושת הנערים וערב פתיחת מבצע "צוק איתן". בתוך ימים מצאתי עצמי מחבר מבזק אחרי מבזק על אזעקת צבע אדום (כמה פעמים כתבתי צבא), דניאל טרגרמן ז"ל והקבינט. הו, הקבינט.
זה היה כמו להכניס את הראש לאמבטיית חשמל. לא שיערתי שאתגלגל להיות ראש דסק, כתב מוניציפלי של אזור ירושלים ולתקופה קצרה גם כתב שטחים ומשפט. ברבות הזמן, דעתי על המקצוע השתנתה לא מעט פעמים. בחלוף ארבע שנים ניסחתי כמה מחשבות שלא השתנו, ועיקרן תחילה: ביקורת על המבקרת הגדולה של החברה הישראלית.
בסגנון ג'רי מגווייר (אמא שלי תמיד אמרה שאני דומה לטום קרוז), אנסה לטעון שהמלכה הגדולה והחשובה, כלבת השמירה של הדמוקרטיה, הרשות הרביעית, אור השמש המחטא, הראשונה לשמה, עירומה. ולו באופן חלקי.
קצת על עצמי לספר ידעתי: אמרי לוי-סדן, עד לפני כמה חודשים כתב ב"וואלה" (מאז הספקתי לעבוד כיועץ התקשורת של גלעד ארדן – ולפרוש בשיא). הייתי עיתונאי ממעמד הביניים של עולם העיתונות. השם שלי מוכר ליודעי ח"ן, למקורותי, למכרי ולכמה טוקבקיסטים וסטוקרים קריפיים במיוחד.
הבאתי כמה סיפורים טובים בקריירה העיתונאית שלי, קיבלתי כמה איומי סרק בתביעות, עבדתי קשה, ואני חושב שהבאתי תוצאות סבירות בהחלט. אבל אם להיות כן, אני לא חושב שהייתי עיתונאי בולט במיוחד או מבריק במיוחד. בסך הכל פועל טוב במפעל. רוב העיתונאים שפגשתי ושאני מכיר הם אנשים מבריקים באמת, חכמים מאוד, חדים, מהירים וחריפי מחשבה, הרבה יותר ממני.
עיתונאים הם אנשים ייחודיים: הם רגילים לעבד כמויות מידע אדירות במהירות, לקרוא סאבטקסט ולהבין דבר מתוך דבר. הם מאומנים בזיהוי בולשיט ושקרים של אנשים אחרים, ביצירת קשרים ובשכנוע. הם סוכני מוסד, מרגלים, בלשים, שופטים, סופרים וקוראי מחשבות. הם זמינים כמו מגן דוד אדום (כל הזמן. ממש כל הזמן. כל רגע ורגע ביום), לפעמים כמו סופרמנים שעפים מזירה מדממת ליישוב בוער, והם שקדנים וסבלניים כמו חיית טרף. לא סתם עיתונאים מככבים דרך קבע בסרטי גיבורי-על: הצלם פיטר פרקר מחלטר כספיידרמן, קלארק קנט מסווה את זהותו כעיתונאי ב"דיילי פלאנט", קים בייסינגר היא צלמת עיתונות שמצליחה לשבות את לבו של באטמן (כשטים ברטון עוד היה בתמונה), ואפריל אוניל היא חברתם הטובה של צבי הנינג'ה.
אני לא בקי בהיסטוריה של מקצוע העיתונאות. אני מניח שדברים רבים השתנו בעידן הווטסאפ והרשתות החברתיות, אבל גם שחלק גדול ממאפייני התחום נותרו ללא שינוי עוד מהמאה ה-19. בישראל 2018, עיתונאים ואנשי תקשורת עושים נסים בכל יום. הם חושפים פרשות שחיתות של ראשי ממשלה, גורמים להדחת קצינים בכירים שביצעו עבירות מין, נאבקים בקרב חסר תוחלת בתאגידים בנקאיים רבי-עוצמה ומגינים על האזרח הקטן. כל זה נכון לחלוטין, ומבקריה של התקשורת צריכים לזכור זאת: התקשורת היא כלי הנשק הטוב ביותר, אור השמש המחטא החזק ביותר שיש כיום נגד הממסד, כל ממסד באשר הוא. התקשורת היא אימפריה של ידע ומידע, סיפורים מעניינים וסכין קטלנית במיוחד שננעצת בבלון. ומלים אלו הן לא מס שפתיים או מליצת יושר.
אולם בהווה ובאקטואליה המקומית שלנו, מקצוע התקשורת הוא גם עדות ברורה וחדה לכל מה שרע בחברה הישראלית. כמו אדם ששואב ארס מגוף חברו שהוכש על-ידי נחש והארס נטמע בתוכו, כך סיפחה לעצמה התקשורת נורמות רעילות שמחלחלות לכל חלקה טובה.
אני בוחר להתחיל דווקא בפרטים הקטנים, באנשים ובהווי היומיום. מקצוע העיתונות גובה מחיר כבד מעובדיו. אותו סקטור רב-השפעה שנלחם נגד כל עוולות העולם לא מצליח לדאוג לאנשיו. הרבה מלים מתוך ה-DSM רלבנטיות לתיאור המצב הנפשי של עיתונאים. אישיות דו-קוטבית, OCD, חרדה, מגלומניה, פוסט-טראומה, אספרגר וטורט. לפעמים, בשעות הקטנות של הלילה, אחרי יום ארוך ומתסכל במיוחד, מופיעה גם הסכיזופרניה. הבחינה הפנימית והמדוקדקת שאינה נגמרת, ההחמרה, ההלקאה העצמית, הצורך לשים לב לכל פרט קטן, הלחץ מהתחרות, ההתמכרות לאדרנלין והתסכול כשהאייטמים לא מגיעים.
אנשים שאינם עיתונאים לא יודעים את זה, אבל הדינמיקה של חיי כתב היא למעשה רכבת הרים מאני-דיפרסיבית. אלא שהמאניה חלשה בהרבה מהדיפרסיה. היא נעלמת אחרי יום, לפעמים אחרי שעה, וכבר מגיע הצורך (שלי ושל המערכת) במנה הבאה. אבל הדיפרסיה מלווה את העיתונאי כל הזמן. כי בתוך תוכם, רוב העיתונאיות והעיתונאים שאני מכיר יודעים שמשהו בהתנהלות הזו לא בסדר, שזו אינה דרך חיים הגיונית ואנושית.
קנאה, שנאה, צרות עין, חמדנות, כוחנות, תככנות, התפארות עצמית, בושה, רמיסת האחר ושמחה לאיד. רק עוד תכונה אחת חסרה כאן: קטנוניות. המלה הזו בעייתית, כי המשמעות שלה גורמת לקורא לחשוב שמדובר בבעיה קטנה, אבל קטנוניות היא אחד משורשי הרע שדבק בתקשורת. היא מה שקורה כשתשומת לב לפרטים – תכונה חיובית ללא ספק – הופכת לאובססיה. היא מה שקורה כשהגוף כבר לא מסוגל להתנתק מהאותיות הקטנות ולראות את התמונה הגדולה. כשיותר מדי סיגריות וכוסות לאטה מרעילות את זרימת הדם ומונעות ממנו לשאת חמצן למוח.
ממלכת הקטנוניות היא הטוויטר, כיכר השוק של עיתונאים, בעלי השפעה ומעריצי הז'אנר. המרחב המושחז ביותר, הרהוט ביותר והמאוס ביותר. מקום שבו טובי המוחות של המקצוע, ואולי גם של מדינת ישראל, מכלים את ימיהם במריבות מטופשות, בעקיצות, בניסיון לגרום למתחריהם להיראות רע, בהטחת עלבונות ובשנינויות אינסופיות.
מדי פעם אני מבחין באיזה נר קטן שמצייץ: "חבר'ה, החלטתי לעשות הפסקה מטוויטר, זה עושה לי רע", אבל זהו רק אור קטן שלא נעשה לו נס. אני מודה שבתחילת הדרך הוקסמתי. אני חושב שהתחושה היתה כמו זו שניאו חש כשנחשף בפניו המטריקס. Mind Blowing אחד גדול. אבל לאט-לאט נצברת התחושה שמשהו לא טוב קורה שם. שבסופו של דבר, מתחת לקדחתנות ולטפלות מסתתרות גם הרבה אלימות ורשעות.
אני חובב של סרטי מאפיה. בסרט "החבר'ה הטובים" יש סצנה נהדרת שבה לוריין בראקו, השחקנית שמגלמת את אשתו של גנגסטר חדש ומצליח (ריי ליוטה), מספרת על נשות אנשי המאפיה. בעודה יושבת עם אחיות הגורל שלה בסלון יופי ומאזינה לסיפוריהן המחרידים היא מתארת לצופים איך מתחת לחזות הנוצצת שלהן ולאיפור היוקרתי מסתתרים כתמי המכות שהן חוטפות מהגנגסטרים. איך, למרות המראה הצעיר, הן מזדקנות מהר יותר מנשים שנישאו לאנשים "משעממים", ואיך הן מצליחות להסוות את האומללות שלהן מעיני הסביבה.
וכך גם במקצוע העיתונות ככלל ובטוויטר בפרט. על פני השטח יש בתחום שלנו הנאה אינטלקטואלית, דרמות, טרגדיות וקומדיות, מידע מעניין ומגוון וחידוד מחשבה אמיתי. אבל כשמאזינים טוב-טוב לטקסטים שרצים בטוויטר מתחילים לשמוע גם קולות אחרים: הקאות, הלקאות והכאות. והגרורות, הגרורות הארורות של סרטן הסופר-אגו וה-OCD צומחות בחשיכה, בין ציוץ לציוץ ובין רפרוש לרפרוש.
את הנחמה מוצאים, אולי, אנשי תקשורת בתחושת השייכות לברנז'ה. הקהילה המדומיינת. תחושת "אנחנו" ו"כולנו". חברות במועדון אקסלוסיבי, איכותי ובעל משמעות. בפועל, זוהי אשליית שייכות לעולם שלמרות ששמו הוא "תקשורת" כמעט ואין בו אינטימיות.
בטיול האחרון לחו"ל ביקרתי במוזיאון עם תעודת עיתונאי שידעתי שאמורה להקנות לי כניסה חינם. לאחר שקיבלתי את האישור מפקידת הקבלה, שמחתי בלבי. הרגשתי שאני חלק מארגון סודי שמאפשר לי גישה למאגרי ידע והשכלה, בונה חופשי של טקסטים ונאורות. אבל גם אז ידעתי שמדובר באילוזיה. אין באמת ארגון שכזה. אחוות עיתונאים סודית קיימת אולי רק ברומנים של אומברטו אקו. המציאות היא, שאדם לאדם זאב, וכלי תקשורת לכלי תקשורת אויב..
הנה זווית נוספת לטענה הזו. תנאי ההעסקה במקצוע העיתונות מחפירים. אנשים שעובדים 14 שעות ביום, מדי יום, כולל סופי שבוע. אנשים שקורעים את התחת, מוקפצים בחגים, שבתות, שמחות משפחתיות ובאמצע הלילה, חיילים לכל דבר ועניין, מרוויחים מעט מאוד מעל הממוצע במשק והרבה פחות מאותם יחצנים זחוחים שמנסים לדחוף להם עוד אייטם האדרה עצמית.
למרות פעילותו המבורכת של ארגון העיתונאים, עדיין מדובר בסקטור שאין מי שדואג לזכויותיו. התאגדות? מאבק למען זכויות העובדים? הדבר היחיד שעיתונאים מסוגלים להגג עליו כאילו הוא בר-חשיבות בעת הזו, הוא מאבק למען חופש העיתונות בטחנת רוח פוליטית, אכזרית ודכאנית שלא נותנת לעיתונאים להביע את דעתם. אבל דאגה ללחם ולחמאה, לאותם מאות ואלפי עיתונאים שמנסים לגדל ילדים בעבודת פרך ומקבלים באופן יחסי, פרוטות – לא מורגשת באמת.
אלו שנמצאים בחלק העליון של טבלת השכר לא זקוקים למאבק שכזה, והיתר, הרוב – כתבים, מפיקים, צלמים, גרפיקאים, עורכים – פשוט חלשים ואנונימיים מכדי לנהל מאבק שכזה. למעשה, הם בעיקר מפחדים. מפחדים לצאת נגד עגל הזהב שכולם סוגדים לו. מפחדים להטיל ספק במקצוע שמטיל ספק בכולם, ורק לא בעצמו.
המשכורת פח והמחיר שמשלמים עיתונאים על אורח החיים הזה גבוה מאוד. הסמארטפונים משפיעים על עיתונאים יותר מכל קבוצה אחרת באוכלוסייה. כמו קרינה על עובדי הכור בדימונה. הנה ניסוי: קחו טלפון של עיתונאי, שימו אותו בצד לחצי שעה ותפתחו את הווטסאפ. אני מניח שהאפילפסיה שתמצאו שם תפתיע אתכם.
כילד, אהבתי מאוד את הסרט "כל אנשי הנשיא" על פרשת ווטרגייט. אבל ברור שכיום לסרט כזה, כמו גם לסרטים עדכניים יותר ("ספוטלייט", "העיתון"), אין זיקה של ממש למציאות. צוותי תחקירנים שעוסקים כל היום בסיפור אחד שבו הם מתעמקים ומתמצאים הם נחלת העבר. המציאות שלנו היא מסך מגע שאי-אפשר לשכוח ממנו ליותר מחמש דקות. תוסיפו טוויטר, פייסבוק, טלגרם, מיילים, כל מה שקורה מחוץ לחיים עצמם, ותקבלו תנועות יד לא רצוניות לכיס, רטטי שווא מדומיינים וצלצולים פורחים באוויר.
זוהי ההקצנה הברוטלית ביותר של חוליי ההתפתחויות הטכנולוגיות של העשור האחרון. המקום שבו הנפש מפנה את מקומה למסך בשביל להשיג אייטם שיוקרן עליו. בשביל לעצור את הטירוף הזה דרושה יותר מהתאגדות עובדים יעילה, או אפילו שינוי באחד מכלי התקשורת. זוהי בעיה תרבותית שנוגעת ישירות לאפיונו של המקצוע בעת הזו. מכירת הבריאות הנפשית תמורת יעילות טכנולוגית, השתעבדות רצונית לאורח חיים לא בריא בעליל, אפילו מזיק במידה רבה, ומבלי לקבל תמורה ראויה.
* * *
בניגוד למה שמנסים בעלי אינטרסים שונים לטעון היום, התקשורת היא לא הסיבה אלא התוצאה. שוק התקשורת הוא שוק פרטי הכפוף לכללי השוק של היצע וביקוש. חטאה של התקשורת הישראלית הוא בהיותה פונדקאית של מחלות ווירוסים שמסתובבים בישראל בשנים האחרונות. היא לא Patient Zero, אבל בהחלט נשאית של הנגיף.
הדמיון בין פרצופה של החברה הישראלית לאופן המוקצן שבו הוא מתגלם בתקשורת נובע בין היתר מהצד השני של המטבע – האנשים שעמם עובדים אנשי תקשורת, "המקורות". יחצנים. עורכי-דין, דוברים, לוביסטים ועוזריהם. כל מיני אנשים משונים שתמונת הפרופיל שלהם היא צילום של עצמם בחליפה ובחולצה מכופתרת בתוכנית בוקר זניחה. אנשים שרואים בפרסום את תכלית חייהם, ומשתמשים בחייהם לתכלית הפרסום. כל אלו שאין להם כוח ממשי, אבל עיסוקם מקרב אותם למוקד הכוח והם נהנים לגנוב את הזהב הכאילו-נוצץ הזה.
כמו בוקסטל, הנבל ברומן "הצבעוני השחור" של אלכסנדר דיומא, הם מנסים להתחכך במוקדי הכוח ובכך לשוות לעצמם חשיבות, ושוכחים שהם לא מגדלים דבר, אלא רק גונבים מעט תהילה מהאלים שהם מייחלים להחליפם. קשה לבלום את הסימביוזה שנוצרת מעבודה תכופה ויומיומית מול אותם אנשים. קשה לא להיות מושפע מנורמות ההתנהגות, צורות החשיבה, הלבוש והסגנון. קשה לא להפוך להיות סוכן שמפיץ את אותן מחלות התנהגותיות שהן כל מה שרע בישראל.
וכך, תוך שיבה לסקטוריאליזם פנאטי, התקשורת מחמיצה את האפשרות שנתניהו ייבחר ולא הרצוג, ולאחר מכן מחמיצה את האפשרות שטראמפ ייבחר ולא הילרי. וזכור לטוב הטור המפורסם של העורכת הציבורית של ה"ניו-יורק טיימס", ליז ספייד, שכותרתו: "רוצים לדעת מה אמריקה חושבת? תנסו לשאול", שבו כתבה על הניתוק בין משאלות הלב של עורכי ה"טיימס" למציאות שמחוץ למקלדת. למרות טיבן של הדוגמאות, ההטיה לא קשורה דווקא למחנה הליברלי או למחנה השמאל, כמו שיש מי שניסו לצייר בישראל, אלא לשיח כוחני, דעתני ולעומתי שעדיין שולט – בשמאל וגם בימין (שממשיך ללבוש בהנאה את בגדי הקורבן הבלויים של השמאל). והנה נבואה: הבחירות הבאות יהיו שידור חוזר מדויק ומועצם פי אלף, אלפיים וארבעת אלפים של הבחירות האחרונות.
ואם בספרות האלפים עסקינן, הרי שהגיע הזמן לגשת לעוד כתם עיוור בשדה הראייה של התקשורת. המקום שבו היא לא רק מסתכלת על המציאות אלא גם משתתפת בה. להווה ידוע שעיקרן של הפרשות שנחקרות כיום בנוגע לראש הממשלה עוסק בתקשורת. לא התקשורת כמי שמביאה את האייטם על פרשת השחיתות, אלא כמי שהיא עצמה אייטם בפרשה. ה"תקשורת" כבעלים של התקשורת. אותם בעלי הון ועיתון ששולחים עיתונאים שמגרדים כמה אלפים בחודש כדי לסקר את הקשר שלהם עצמם, המיליארדרים, עם בנימין נתניהו.
התקשורת כאותו מחול שדים שבו המספר מגולל סיפור על עצמו במעין ארס פואטיקה לא פואטית ולא מודעת לעצמה. התקשורת בריבוי התפקידים ובגילוי העריות כמראה שעל הקיר, כמלכה החורגת הקנאית וכשלגייה הצחורה משלג. התקשורת כהכלאה של ניו-ג'ורנליזם, פוסט-מודרניזם, אנכרוניזם ווואטאבאוטיזם (והסלידה ממנו כמובן!). התקשורת כסיבה לבחירות 2015 – "חוק 'ישראל היום'" – והתקשורת כסיבה העקיפה לבחירות הבאות.
פוזיציה של סיקור אובייקטיבי מעל הגדר מתה מזמן. העיתונאים מעורבים, מיודדים, מתמנגלים, מסתמסים, מתרטווטים עם מושאי הסיקור שלהם. הבחירות הן אורגיית הדעות והציוצים הגדולה שמתרחשת אחת לכמה שנים. בדרך עוברים מאורגזמה לאורגזמה, עוצרים לפעמים כדי לתהות על תכלית הכל ושוב צוללים פנימה, ליוון השכחה.
מרוב אינטנסיביות, מקוצר רוח ומעבודה קשה, התקשורת הישראלית לא מצליחה להתרומם ולדון בגורלה ובעתידה. האם לא הגיעה העת לעצור לרגע את הרכבת? לבצע בדק בית יסודי? יום עיון? אינטרוונשן? אם 2000 ו-4000 לא מספיקים (וגם 1000 הוא חלק מהעניין למעשה) כדי להפוך לקו פרשת מים, אז מה כן?
אם לתקשורת יש היום תפקיד קריטי ומהותי, הוא לא מתמצה בחשיפת פרשת שחיתות שלטונית כזו או אחרת, אלא בניסיון להוביל מהלך, אנטי-כלכלי, אנטי-קפיטליסטי, ולקרוא תיגר על עצמה. להפסיק לשרת את כל אותם אינטרסנטים מקדמי עצמם, טרולים רודפי פרסום ומוצצי לשד, לחדול מהעברת מסרי שוליים קיצוניים ולנסות לבנות מחדש מרכז כובד ועמוד שדרה סביב ערכי השפיות.
כמעט שום דבר ממה שתואר כאן הוא לא באשמתה של התקשורת. היא לא הרתה ולא ילדה את המצב הנוכחי. היא מספקת היצע לביקוש שמשום מה מסרב לרדת. זו לא אשמתה, אבל זו אולי ההזדמנות הגדולה ביותר שלה. לחזור ולהבחין בין עיקר לטפל, בין רדוד לעמוק ושטחי וגבוה. לחזור ולהיאבק באוכלי הנבלות והפגרים, בשותי הדם והמוצצים. לחזור ולהילחם על זכותו ההיסטורית של העם היהודי לתקשר.
(פורסם במקור באתר העין השביעית)